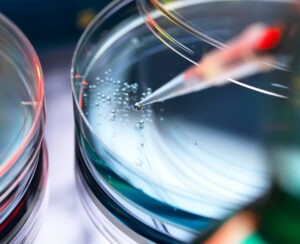
Understanding H. Pylori: Symptoms and Treatment Explained

Mental Health & Emotional Wellness
Taking care of your emotional well-being is just as important as caring for your body. How we think, feel, and respond to life’s challenges shapes our overall health and happiness. Emotional wellness doesn’t mean feeling happy all the time — it means learning to understand your emotions, manage stress, and find balance even during difficult moments.
Browse In-Depth Guides
Understanding H. Pylori: Symptoms and Treatment Explained
April 6, 2026 | by admin
Helicobacter pylori, often shortened to H. pylori, is a type of bacterium that can infect the stomach lining. Though it’s...
Read More →